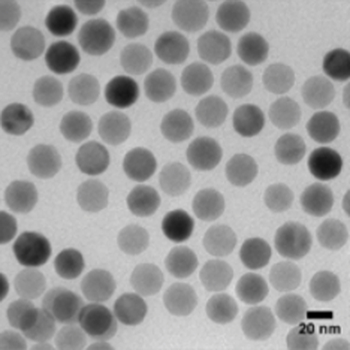
Biosensis PrecisionMRX.png

AGENT BRAND
品牌專題
我們很高興推出PrecisionMRXSPIONs -超順磁性氧化鐵納米顆粒(Superparamagnetic Iron Oxide Nanoparticles )(SPIONs),專為最苛刻的生命科學(xué)研究應(yīng)用而設(shè)計(jì)。Biosensis現(xiàn)在提供我們認(rèn)為是世界上最好的SPIONs用于研究,我們希望您是第一個(gè)知道的。

為什么選擇SPIONs?
如果您以前沒有使用過SPIONs,這里有一個(gè)快速概述:
√超順磁性:一旦移除了外部磁場,SPIONs就沒有剩余的磁性,確保了高靈敏度而沒有粒子聚集。
√多功能性:SPIONs具有多種功能,包括MRI造影劑(T?/T?*),磁分離珠,熱療加熱器,MPI示蹤劑,松弛探頭等。
√生物相容性:鐵,人體內(nèi)的天然元素,結(jié)合我們的專業(yè)涂層,確保膠體穩(wěn)定性,低毒性,易于功能化。
四種格式,一個(gè)SPION平臺
我們提供四種不同的PrecisionMRX格式,以便您可以為您的研究目標(biāo)選擇完美的工具
格式 | 關(guān)鍵特性 | 使用例子 |
油酸包覆 | 疏水,可溶于非極性有機(jī)溶劑 | 磁熱療1疫苗佐劑2,3 |
羧酸功能化 | 共價(jià)偶聯(lián)的-COOH基團(tuán) | 生物偶聯(lián),細(xì)胞標(biāo)記和跟蹤,藥物/基因傳遞 |
mPEG涂層 | “隱形”PEG外殼,體內(nèi)血液半衰期長” | 體內(nèi)MRI 5/MPI 6,超低場MRI 7,8,給藥 |
葡聚糖涂 | 右旋糖酐表面帶正電荷 | 細(xì)胞標(biāo)記和跟蹤,MRI對比 |
沒有找到你想要的?聯(lián)系我們,我們可以為您定制產(chǎn)品!
為什么Biosensis PrecisionMRXSPIONs是最好的
|  |
精確、均勻、一致
Biosensis PrecisionMRX納米顆粒是超順磁性氧化鐵納米顆粒,具有均勻的球形形態(tài),窄尺寸分散性和高磁弛豫率。PrecisionMRX納米顆粒通過小角度x射線散射(SAXS)和透射電子顯微鏡(TEM)進(jìn)行廣泛表征,以確保磁鐵礦巖心具有均勻的球形形貌,大小一致,分散性小。

更高的飽和磁化強(qiáng)度
PrecisionMRX納米顆粒的飽和磁化強(qiáng)度是傳統(tǒng)納米顆粒的2倍。

在低磁場下,PrecisionMRX氧化鐵納米顆粒的磁化強(qiáng)度大大超過傳統(tǒng)的納米顆粒。

更好的磁共振成像技術(shù)
我們的超順磁性氧化鐵納米顆粒增強(qiáng)了MRI中的T2弛豫和T2*信號。PrecisionMRX納米顆粒的高磁化率允許傳統(tǒng)造影劑無法提供的獨(dú)特的弛豫性和敏感性效應(yīng)。


微信掃碼在線客服